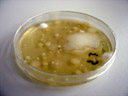

to weeks ago, i attended a week-long practical course, dedicated to the basics of microbiologic laboratory work.
we did pretty cool stuff, including the sampling various objects for their microbial count, extract bacteria and fungi from soil, checking germ numbers of milk and water, isolating and using phages (viruses that infect bacteria), …
interesting fact: metal items such as door handles are basically self-disinfecting (regarding heterogeneous bacteria), because metals affect/deactivate most enzymes.
the two professors pretty soon knew me as “the one who takes lots of photos”. in the end, prof. m. even suggested taking photos during the final test, and did so herself. :-)